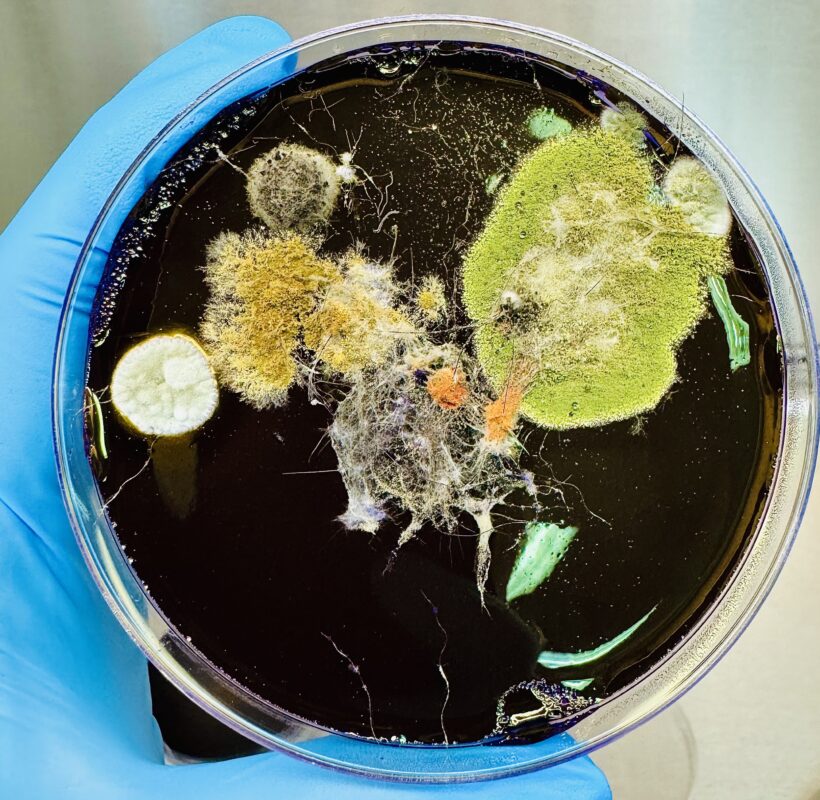

Title: Ecosistemas Invisibles:: Diversidad de Hongos en el Pelaje de Perros
Votes: ?
Category: Investigación Científica y Tecnológica
Views: ?
Description: Esta imagen muestra el resultado de sembrar pelos de perros sanos en agar Littman, donde, tras varios días de incubación, emergen diversas colonias de hongos comensales y saprofitos. Estos microorganismos coexisten naturalmente en el pelaje canino sin causar enfermedad, reflejando el equilibrio ecológico entre el animal y su entorno. Su presencia es crucial en la descomposición y el reciclaje de materia orgánica, y su estudio ayuda a comprender la compleja interacción microbiológica que sostiene la salud animal y ambiental. La metodología empleada en esta investigación surgió de la iniciativa del Dr. Francisco Rivas.